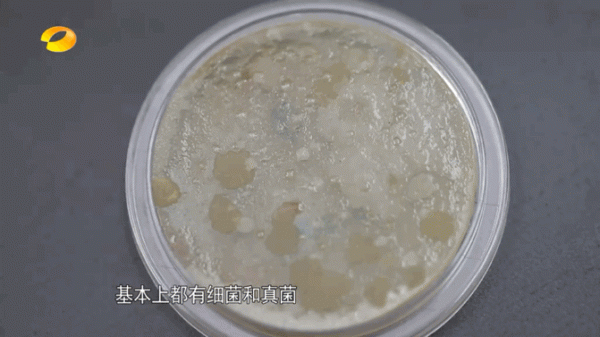
髒!一塊抹布居然引發全家中毒 髒!一塊抹布居然引發全家中毒

真的有被嚇到!
最近看了一篇央視專題報道,沒想到抹布還能這麼“心狠手辣”。
居然能導致全家中毒!
原因是做飯時用抹布擦過魚之後,又擦黃瓜,生黃瓜因為沾了抹布細菌,吃後嘔吐腹瀉,引發了集體性食物中毒
很不可思議!因為在我們的印象中:
抹布只是很髒、油膩膩的不想碰,還有一股特別難聞的臭味而已,原來會有這麼嚴重的後果?
下面說的大家會更想吐!
如果你家的抹布用到發黑、破洞都不換,早就髒如“臭水溝”,成為細菌的“窩藏點”!
中南大學湘雅醫院感染控制中心實驗室曾對抹布進行檢測,致病菌檢出了19種,還在密集蠕動著...
中華預防醫學會也說過:
一條新抹布使用5天,比馬桶還髒!
令人噁心的還有這兒:
每次用抹布擦了灶臺、檯面、油煙機後,即使放了洗潔精用力搓也是很髒很臭,手也變油、變臭、變糙。在廚房隨便一掛就算天天洗、月月換還是容易發黴
大家都普遍有個壞習慣: 抹布一擦到底、一布多用 擦完灶臺、檯面,又擦杯子
你以為擦乾淨了嗎
但實際上卻把病菌抹得更勻、更髒了
家裡到處都是!
你想想這麼多細菌擦過你吃飯的鍋、碗、筷子...你還能吃得下飯?
《中國家庭廚房衛生調查白皮書》中指出:
會引起腹瀉、嘔吐、尤其是小孩老人孕婦更容易生病!
可以說,一條抹布關於到衛生和家人的健康,是真的不能忽略。
難道要擦餐桌一個、灶臺一個、水池一個??
一個廚房至少要準備5塊抹布,這些抹布擦完還必須要清洗乾淨??
作為一個懶人,我做不到,我真的做不到!
大家有什麼好的建議嗎?[呲牙]